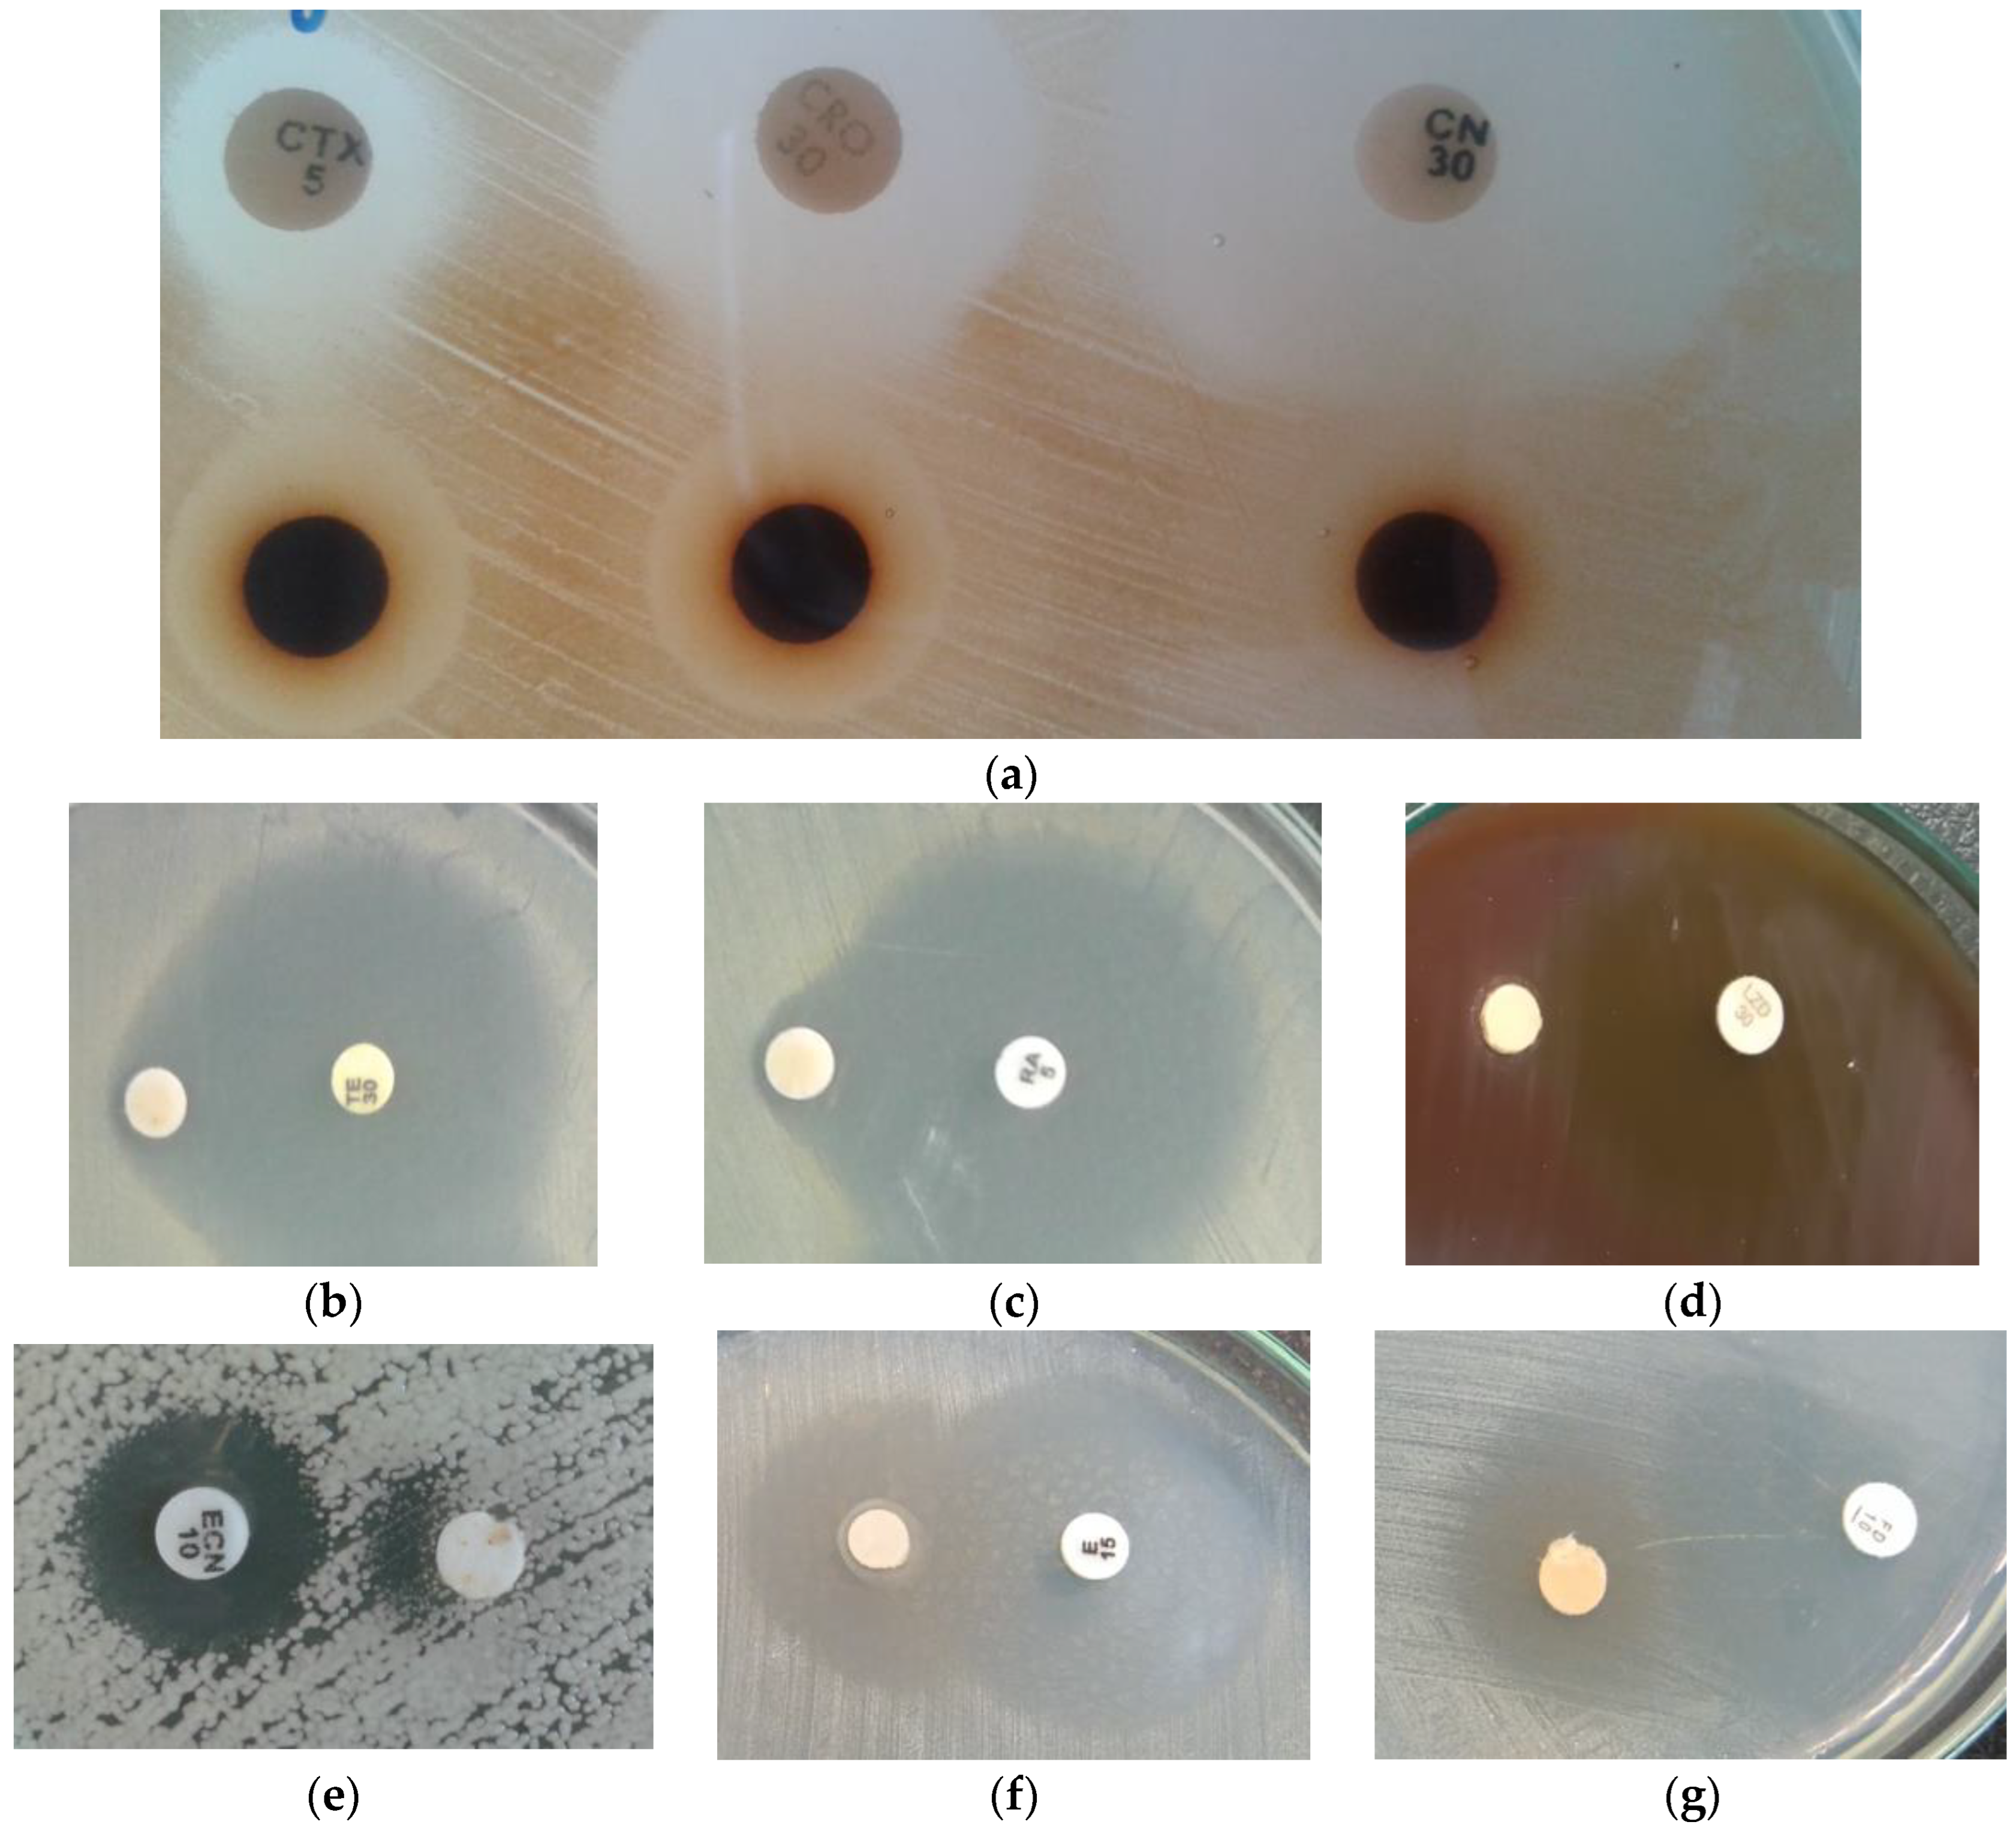
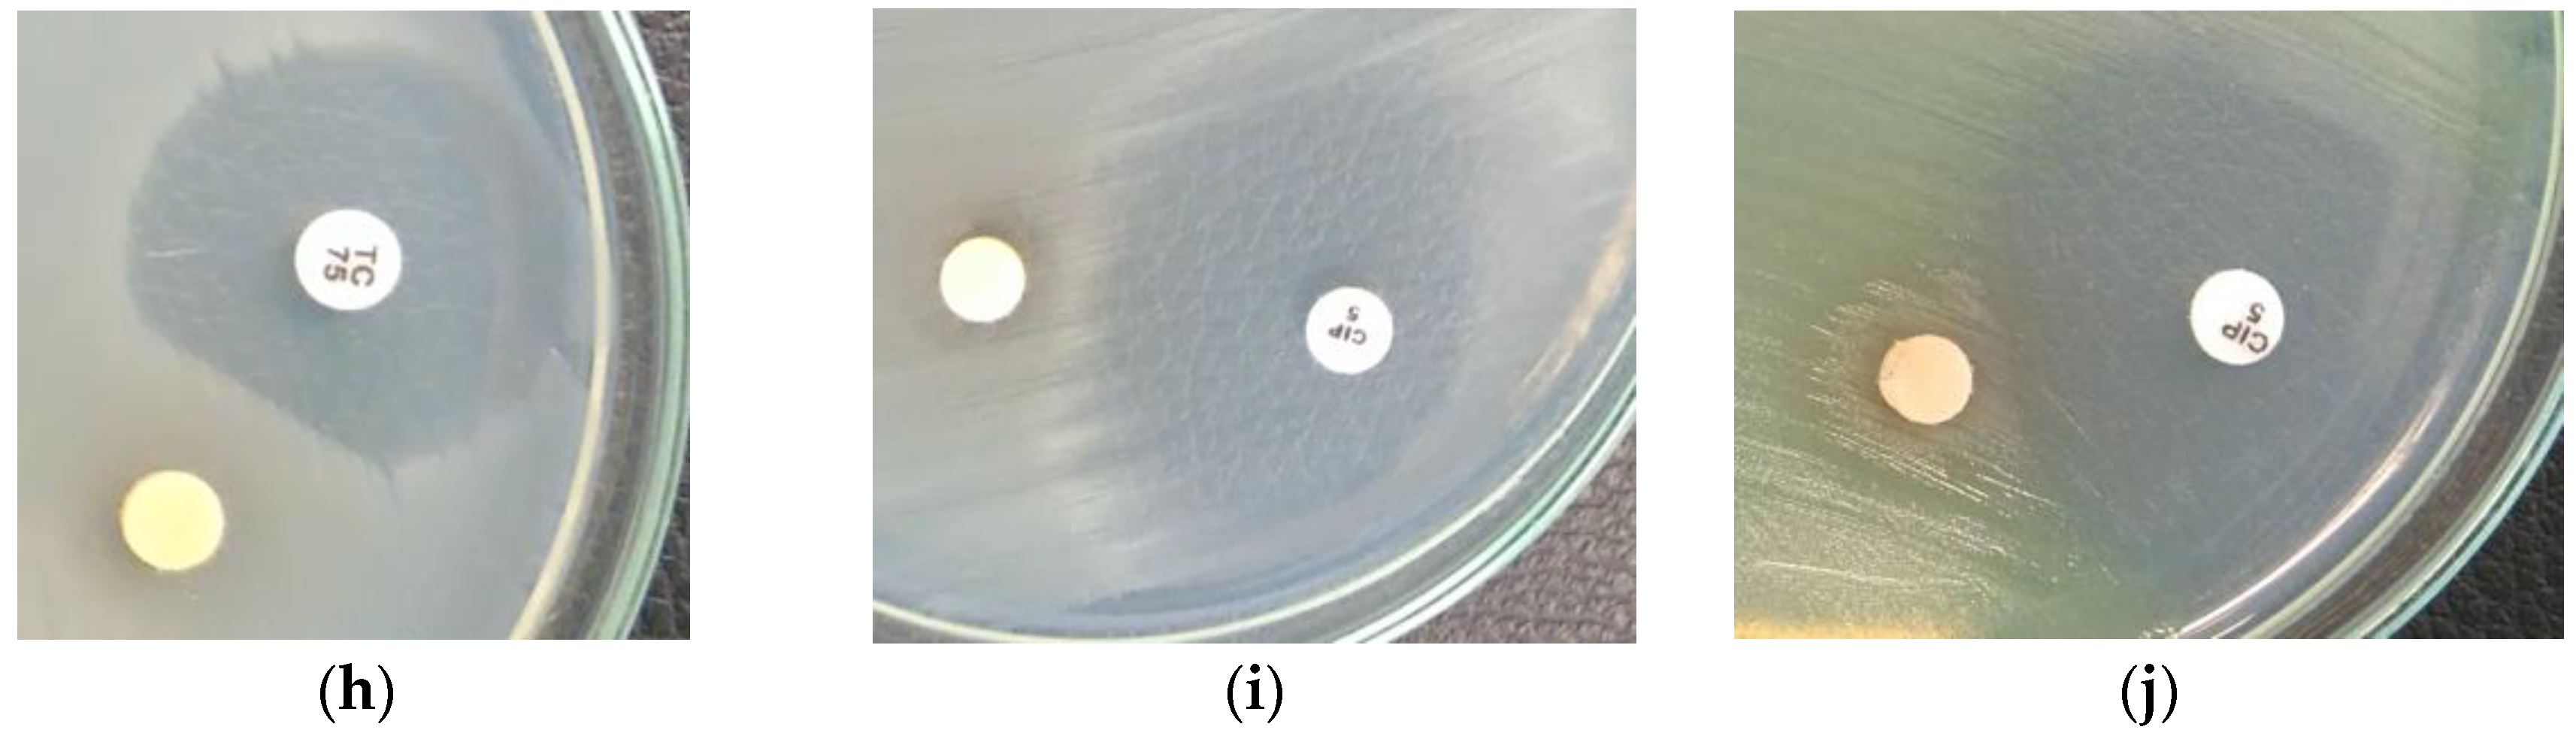

Screening Tests for the Interaction of Rubus idaeus and Rubus occidentalis Extracts with Antibiotics against Gram-Positive and Gram-Negative Human Pathogens
Abstract
1. Introduction
2. Results
2.1. Extract Preparation and Phytochemical Analysis
2.2. Determination of Susceptibility to Antibiotics by Agar Disk Diffusion Method
2.3. Screening for Antibiotic–Extract Interactions Using the Double-Disk Synergy Test (DDST)
3. Materials and Methods
3.1. Strains, Growth Medium, Antibiotics
3.2. Preparation of Extracts
3.3. Determination of Susceptibility to Antibiotics by the Agar Disk Diffusion Method
3.4. Screening for Extract–Antibiotic Interactions Using a Double-Disk Synergy Test (DDST)
3.5. Statistical Analysis
4. Discussion
5. Conclusions
Author Contributions
Funding
Institutional Review Board Statement
Informed Consent Statement
Data Availability Statement
Acknowledgments
Conflicts of Interest
References
- Vaou, N.; Stavropoulou, E.; Voidarou, C.; Tsakris, Z.; Rozos, G.; Tsigalou, C.; Bezirtzoglou, E. Interactions between Medical Plant-Derived Bioactive Compounds: Focus on Antimicrobial Combination Effects. Antibiotics 2022, 11, 1014. [Google Scholar] [CrossRef] [PubMed]
- Bubonja-Šonje, M.; Knežević, S.; Abram, M. Challenges to antimicrobial susceptibility testing of plant-derived polyphenolic compounds. Arh. Hig. Rada. Toksikol. 2020, 71, 300–311. [Google Scholar] [CrossRef] [PubMed]
- Cowan, M.M. Plant products as antimicrobial agents. Clin. Microbiol. Rev. 1999, 12, 564–582. [Google Scholar] [CrossRef] [PubMed]
- Barbieri, R.; Coppo, E.; Marchese, A.; Daglia, M.; Sobarzo-Sánchez, E.; Nabavi, S.F.; Nabavi, S.M. Phytochemicals for human disease: An update on plant-derived compounds antibacterial activity. Microbiol. Res. 2017, 196, 44–68. [Google Scholar] [CrossRef] [PubMed]
- Cheesman, M.J.; Ilanko, A.; Blonk, B.; Cock, I.E. Developing new antimicrobial therapies: Are synergistic combinations of plant extracts/compounds with conventional antibiotics the solution? Pharmacogn. Rev. 2017, 11, 57–72. [Google Scholar] [CrossRef] [PubMed]
- Ertürk, Ö. Antibacterial and antifungal activity of ethanolic extracts from eleven spice plants. Biologia 2006, 61, 275–278. [Google Scholar] [CrossRef]
- Matuschek, E.; Brown, D.F.; Kahlmeter, G. Development of the EUCAST disk diffusion antimicrobial susceptibility testing method and its implementation in routine microbiology laboratories. Clin. Microbiol. Infect. 2014, 20, 255–266. [Google Scholar] [CrossRef] [PubMed]
- Assam, J.P.; Dzoyem, J.P.; Pieme, C.A.; Penlap, V.B. In vitro antibacterial activity and acute toxicity studies of aqueous-methanol extract of Sida rhombifolia Linn. (Malvaceae). BMC Complement. Altern. Med. 2010, 10, 40. [Google Scholar] [CrossRef] [PubMed]
- Bilal, M.; Rasheed, T.; Iqbal, H.M.N.; Hu, H.; Wang, W.; Zhang, X. Macromolecular agents with antimicrobial potentialities: A drive to combat antimicrobial resistance. Int. J. Biol. Macroml. 2017, 103, 554–574. [Google Scholar] [CrossRef] [PubMed]
- Salem, M.Z.; Ali, H.M.; El-Shanhorey, N.A.; Abdel-Megeed, A. Evaluation ofextracts and essential oil from Callistemon viminalis leaves: Antibacterialand antioxidant activities, total phenolic. Asian Pac. J. Trop. Med. 2013, 6, 785–791. [Google Scholar] [CrossRef]
- AlSheikh, H.M.A.; Sultan, I.; Kumar, V.; Rather, I.A.; Al-Sheikh, H.; Jan, A.T.; Haq, Q.M.R. Plant-Based Phytochemicals as Possible Alternative to Antibiotics in Combating Bacterial Drug Resistance. Antibiotics 2020, 9, 480. [Google Scholar] [CrossRef] [PubMed]
- EUCAST. Clinical Breakpoints-Breakpoints and Guidance. Available online: https://www.eucast.org/clinical_breakpoints (accessed on 2 January 2020).
- EUCAST. Guidelines for Detection of Resistance Mechanisms and Specific Resistances of Clinical and/or Epidemiological Importance. Available online: https://www.eucast.org/resistance_mechanisms (accessed on 1 July 2017).
- Verschelden, G.; Noeparast, M.; Stoefs, A.; Van Honacker, E.; Vandoorslaer, K.; Vandervore, L.; Olbrecht, M.; Van Damme, K.; Demuyser, T.; Piérard, D.; et al. Aztreonam-avibactam synergy, a validation and comparison of diagnostic tools. Front.Microbiol. 2023, 14, 1322180. [Google Scholar] [CrossRef] [PubMed]
- Klančnik, A.; Piskernik, S.; Jeršek, B.; Smole Možina, S. Evaluation of diffusion and dilution methods to determine the antibacterial activity of plant extracts. J. Microbiol. Methods 2010, 81, 121–126. [Google Scholar] [CrossRef] [PubMed]
- Brennan-Krohn, T.; Kirby, J.E. When One Drug Is Not Enough: Context, Methodology, and Future Prospects in Antibacterial Synergy Testing. Clin. Lab. Med. 2019, 39, 345–358. [Google Scholar] [CrossRef] [PubMed]
- Hałasa, R.; Turecka, K.; Mizerska, U.; Krauze-Baranowska, M. Anti-Helicobacter pylori Biofilm Extracts from Rubus idaeus and Rubus occidentalis. Pharmaceutics 2024, 16, 501. [Google Scholar] [CrossRef] [PubMed]
- Baran, A.; Kwiatkowska, A.; Potocki, L. Antibiotics and Bacterial Resistance—A Short Story of an Endless Arms Race. Int. J. Mol. Sci. 2023, 24, 5777. [Google Scholar] [CrossRef]
- Gajdács, M.; Albericio, F. Antibiotic Resistance: From the Bench to Patients. Antibiotics 2019, 8, 129. [Google Scholar] [CrossRef] [PubMed]
- World Health Organization. Antimicrobial Resistance: Global Report on Surveillance; World Health Organization: Geneva, Switzerland, 2014; Available online: https://apps.who.int/iris/handle/10665/112642 (accessed on 19 December 2021).
- Lack of New Antibiotics Threatens Global Efforts to Contain Drug-Resistant Infections. Available online: https://www.who.int/news/item/17-01-2020-lack-of-new-antibiotics-threatens-global-efforts-to-contain-drug-resistant-infections (accessed on 19 December 2021).
- CDC’s Antibiotic Resistance Threats in the United States (2019 AR Threats Report). 2019. Available online: https://www.cdc.gov/drugresistance/biggest-threats.html (accessed on 19 December 2021).
- Antimicrobial Resistance: Tackling a Crisis for the Health and Wealth of Nations/the Review on Antimicrobial Resistance chairedby Jim O’Neill.|Wellcome Collection. Available online: https://wellcomecollection.org/works/rdpck35v (accessed on 19 December 2021).
- Ferdes, M. Antimicrobial compounds from plants. In Fighting Antimicrobial Resistance; Budimir, A., Ed.; IAPC-OBP: Zagreb, Croatia, 2018; pp. 243–271. [Google Scholar]
- Djilani, A.; Dicko, A. The therapeutic benefits of essential oils. In Nutrition, Well-Being and Health; Bouayed, J., Bohn, T., Eds.; Well-Being Health 7; IntechOpen: Rijeka, Croatia, 2012; pp. 155–179. [Google Scholar]
- Bubonja-Sonje, M.; Giacometti, J.; Abram, M. Antioxidant and antilisterial activity of olive oil, cocoa and rosemary extract polyphenols. Food Chem. 2011, 127, 821–827. [Google Scholar] [CrossRef]
- King, T.; Dykes, G.; Kristianti, R. Comparative evaluation of methods commonly used to determine antimicrobial susceptibility to plant extracts and phenolic compounds. JAOAC Int. 2008, 91, 1423–1429. [Google Scholar] [CrossRef]
- Valgas, C.; de Souza, S.M.; Smânia, E.; Smânia, A. Screening methods to determine antibacterial activity of natural products. Braz. J. Microbiol. 2007, 38, 369–380. [Google Scholar] [CrossRef]
- Farha, A.K.; Yang, Q.-Q.; Kim, G.; Li, H.-B.; Zhu, F.; Liu, H.-Y.; Gan, R.-Y.; Corke, H.; Kim, G.; Li, H.-B.; et al. Tannins as an alternative to antibiotics. Food Biosience 2020, 38, 100751. [Google Scholar] [CrossRef]
- Dwivedi, G.R.; Tiwari, N.; Singh, A.; Kumar, A.; Roy, S.; Negi, A.S.; Pal, A.; Chanda, D.; Sharma, A.; Darokar, M.P. Gallic acid-based indanone derivative interacts synergistically with tetracycline by inhibiting efflux pump in multidrug resistant . Ecoli. Appl. Microbiol. Biotechnol. 2016, 100, 2311–2325. [Google Scholar] [CrossRef] [PubMed]
- Alibi, S.; Crespo, D.; Navas, J. Plant-Derivatives Small Molecules with Antibacterial Activity. Antibiotics 2021, 10, 231. [Google Scholar] [CrossRef] [PubMed]
- Oulahal, N.; Degraeve, P. Phenolic-Rich Plant Extracts With Antimicrobial Activity: An Alternative to Food Preservatives and Biocides? Front. Microbiol. 2022, 12, 753518. [Google Scholar] [CrossRef] [PubMed]
- Shin, J.; Prabhakaran, V.-S.; Kim, K.-S. The multi-faceted potential of plant-derived metabolites as antimicrobial agents against multidrug-resistant pathogens. Microb. Pathog. 2018, 116, 209–214. [Google Scholar] [CrossRef]
- Saavedra, M.J.; Borges, A.; Dias, C.; Aires, A.; Bennett, R.N.; Rosa, E.S.; Simões, M. Antimicrobial activity of phenolics and glucosinolate hydrolysis products and their synergy with streptomycin against pathogenic bacteria. Med. Chem. 2010, 6, 174–183. [Google Scholar] [CrossRef] [PubMed]
- Martini, S.; D’Addariob, C.; Colacevichc, A.; Focardi, S.; Borghinic, F.; Santuccid, A.; Figurae, N.; Rossi, C. Antimicrobial activity against Helicobacter pylori strains and antioxidant properties of blackberry leaves (Rubus ulmifolius) and isolated compounds. Int. J. Antimicrob. Agents 2009, 34, 50–59. [Google Scholar] [CrossRef] [PubMed]
- Górniak, I.; Bartoszewski, R.; Króliczewski, J. Comprehensive review of antimicrobial activities of plant flavonoids. Phytochem. Rev. 2019, 18, 241–272. [Google Scholar] [CrossRef]
- Wang, S.; Yao, J.; Zhou, B.; Yang, J.; Chaudry, M.T.; Wang, M.; Fenglin, X.; Li, Y.; Yin, W. Bacteriostatic effect of quercetin as an antibiotic alternative in vivo and its antibacterial mechanism in vitro. J. Food Prot. 2018, 81, 68–78. [Google Scholar] [CrossRef] [PubMed]
- Miklasińska-Majdanik, M.; Kępa, M.; Wojtyczka, R.D.; Idzik, D.; Wąsik, T.J. Phenolic Compounds Diminish Antibiotic Resistance of Staphylococcus aureus Clinical Strains. Int. J. Environ. Res. Public Health 2018, 15, 2321. [Google Scholar] [CrossRef]
- Álvarez-Martínez, F.J.; Barraj’on-Catal’an, E.; Herranz-L’opez, M.; Micol, V. Antibacterial plant compounds, extracts and essential oils: An updated review on their effects and putative mechanisms of action. Phytomedicine 2021, 90, 153626. [Google Scholar] [CrossRef] [PubMed]
- Siriwong, S.; Teethaisong, Y.; Thumanu, K.; Dunkhunthod, B.; Eumkeb, G. The synergy and mode of action of quercetin plus amoxicillin against amoxicillin-resistant Staphylococcus epidermidis. BMC Pharmacol. Toxicol. 2016, 17, 39. [Google Scholar] [CrossRef] [PubMed]
- Kepa, M.; Miklasinska-Majdanik, M.; Wojtyczka, R.D.; Idzik, D.; Korzeniowski, K.; Smolen-Dzirba, J.; Wasik, T.J. Antimicrobial Potential of Caffeic Acid against Staphylococcus aureus Clinical Strains. Biomed. Res. Int. 2018, 2018, 7413504. [Google Scholar] [CrossRef]
- Siriwong, S.; Thumanu, K.; Hengpratom, T.; Eumkeb, G. Synergy and mode of action of ceftazidime plus quercetin or luteolin on Streptococcus pyogenes. Evid. Based Complement. Alternat. Med. 2015, 2015, 759459. [Google Scholar] [CrossRef] [PubMed]
- Zhao, W.H.; Hu, Z.Q.; Okubo, S.; Hara, Y.; Shimamura, T. Mechanism of synergy between epigallocatechin gallate and beta-lactams against methicillin-resistant Staphylococcus aureus. Antimicrob. Agents Chemother. 2001, 45, 1737–1742. [Google Scholar] [CrossRef] [PubMed]
- Zhao, W.H.; Hu, Z.Q.; Okubo, S.; Hara, Y.; Shimamura, T. Inhibition of penicillinase by epigallocatechin gallate resulting in restoration of antibacterial activity of penicillin against penicillinase-producing Staphylococcus aureus. Antimicrob. Agents Chemother. 2002, 46, 2266–2268. [Google Scholar] [CrossRef] [PubMed]
- Novy, P.; Rondevaldova, J.; Kourimska, L.; Kokoska, L. Synergistic interactions of epigallocatechin gallate and oxytetracycline against various drug resistant Staphylococcus aureus strains in vitro. Phytomedicine 2013, 20, 432–435. [Google Scholar] [CrossRef] [PubMed]
- Hu, Z.Q.; Zhao, W.H.; Asano, N.; Yoda, Y.; Hara, Y.; Shimamura, T. Epigallocatechin gallate synergistically enhances the activity of carbapenems against methicillin-resistant. Antimicrob. Agents Chemother. 2002, 46, 558–560. [Google Scholar] [CrossRef] [PubMed]
- Cho, Y.S.; Schiller, N.L.; Oh, K.H. Antibacterial effects of green tea polyphenols on clinical isolates of methicillin-resistant Staphylococcus aureus. Curr. Microbiol. 2008, 57, 542–546. [Google Scholar] [CrossRef] [PubMed]
- Sudano Roccaro, A.; Blanco, A.R.; Giuliano, F.; Rusciano, D.; Enea, V. Epigallocatechin-gallate enhances the activity of tetracycline in staphylococci by inhibiting its efflux from bacterial cells. Antimicrob. Agents Chemother. 2004, 48, 1968–1973. [Google Scholar] [CrossRef] [PubMed]
- Miklasińska, M.; Kępa, M.; Wojtyczka, R.D.; Idzik, D.; Zdebik, A.; Orlewska, K.; Wąsik, T.J. Antibacterial activity of protocatechuic acid ethyl ester on Staphylococcus aureus clinical strains alone and in combination with antistaphylococcal drugs. Molecules 2015, 20, 13536–13549. [Google Scholar] [CrossRef]
- Lin, R.D.; Chin, Y.P.; Hou, W.C.; Lee, M.H. The effects of antibiotics combined with natural polyphenols against clinical methicillin-resistant Staphylococcus aureus (MRSA). Planta Med. 2008, 74, 840–846. [Google Scholar] [CrossRef] [PubMed]
- Zhang, L.; Kong, Y.; Wu, D.; Zhang, H.; Wu, J.; Chen, J.; Ding, J.; Hu, L.; Jiang, H.; Shen, X. Three flavonoids targeting the beta-hydroxyacyl-acyl carrier protein dehydratase from Helicobacter pylori: Crystal structure characterization with enzymatic inhibition assay. Protein Sci. 2008, 17, 1971–1978. [Google Scholar] [CrossRef] [PubMed]
- Lu, M.; Li, T.; Wan, J.; Li, X.; Yuan, L.; Sun, S. Antifungal effects of phytocompounds on Candida species alone and in combination with fluconazole. Int. J. Antimicrob. Agents 2017, 49, 125–136. [Google Scholar] [CrossRef] [PubMed]
- Veras, H.; Santos, I.; Santos, A.; Matias, E.; Leite, G.; Souza, H.; Costa, J.; Coutinho, H. Comparative evaluation of antibiotic and antibiotic modifying activity of quercetin and isoquercetin in vitro. Curr. Top. Nutraceut Res. 2011, 9, 25–30. [Google Scholar]
- Capaldi, R.A.; Aggeler, R. Mechanism of the F1F0-type ATP synthase, a biological rotary motor. Trends Biochem. Sci. 2002, 27, 154–160. [Google Scholar] [CrossRef] [PubMed]
- Bernard, F.X.; Sable, S.; Cameron, B.; Provost, J.; Desnottes, J.F.; Crouzet, J.; Blanche, F. Glycosylated flavones as selective inhibitors of topoisomerase IV. Antimicrob. Agents. Chemother. 1997, 41, 992–998. [Google Scholar] [CrossRef] [PubMed]
- Ohemeng, K.A.; Schwender, C.F.; Fu, K.P.; Barrett, J.F. DNA gyrase inhibitory and antibacterial activity of some flavones. Bioorg. Med. Chem. Lett. 1993, 3, 25–230. [Google Scholar] [CrossRef]
- Suriyanarayanan, B.; Shanmugam, K.; Santhosh, R. Synthetic quercetin inhibits mycobacterial growth possibly by interacting with DNA gyrase. Rom. Biotechnol. Lett. 2013, 18, 1587–1593. [Google Scholar]
- Abraham, E.P. An Enzyme from Bacteria able to Destroy Penicillin. Nature 1940, 146, 837. [Google Scholar] [CrossRef]
- Wise, E.M.; Park, J.T. Penicillin: Its basic site of action as an inhibitor of a peptide cross-linking reaction in cell wall mucopeptide synthesis. Proc. Natl. Acad. Sci. USA 1965, 54, 75–81. [Google Scholar] [CrossRef]
- Hayek, S.A.; Gyawali, R.; Ibrahim, S.A. Antimicrobial natural products. In Microbial Pathogens and Strategies for Combating Them: Science, Technology and Education; Mendez-Vilas, A., Ed.; FORMATEX: Badajoz, Spain, 2013; Volume 2, pp. 910–921. [Google Scholar]
- Pisoschi, A.M.; Cimpeanu, C.; Predoi, G. Electrochemical methods for total antioxidant capacity and its main contributors determination: A review. Open Chem. 2015, 13, 824–856. [Google Scholar] [CrossRef]
- Nichita, C.; Neagu, G.; Cucu, A.; Vulturescu, V.; Bertesteanu, S.V.G. Antioxidative properties of Plantago lanceolata L. extracts evaluated by chemiluminiscence method. AgroLife Sci. J. 2016, 5, 95–102. [Google Scholar]
- Pisoschi, A.M.; Pop, A.; Georgescu, C.; Turcus, V.; Olah, N.K.; Mathem, E. An overview of natural antimicrobials role in food. Eur. J. Med. Chem. 2018, 143, 922–935. [Google Scholar] [CrossRef] [PubMed]
- Mann, C.M.; Markham, J.L. A new method for determining the minimum inhibitory concentration of essential oils. J. Appl. Microbiol. 1998, 84, 538–544. [Google Scholar] [CrossRef] [PubMed]

| Chemical Compound | Fruits R. id. “PR” | Fruits R. id. “Lasz” | Fruits R. occ. “Lit” | Shoots R. id “Will” |
|---|---|---|---|---|
| Ellagic acid | 32.1 | 24.6 | 29.6 | 455.6 |
| Ellagic acid derivatives | ||||
| Ellagic acid pentoside | 26.8 | 56.4 | 23.5 | 195.1 |
| Ellagic acid methylpentoside 1 | 24.5 | 22.9 | 27.9 | 51.6 |
| Ellagic acid acetylpentoside 1 | 21 | 22.7 | 20.6 | 174.0 |
| Sum of contents | 72.3 | 102.0 | 72.0 | 420.7 |
| Ellagitannins | ||||
| Sanguiin H-2 1 | 19.9 | 20.0 | 19.7 | 44.3 |
| Sanguiin H-6 1 | 140.5 | 189.0 | 82.9 | 339.5 |
| Sanguiin H-10 isomer 1 | 132.8 | 84.3 | 116.1 | 183.6 |
| Lambertianin C 1 | – | – | – | 31.1 |
| Sum of contents | 293.2 | 293.3 | 218.7 | 598.5 |
| Anthocyanins | ||||
| Cyanidin 3-O-glucoside | – | 56.4 | 253.1 | – |
| Cyanidin 3-O-rutinoside 2 | – | 14.0 | 1195.0 | – |
| Cyanidin 3-O-sophoroside 2 | – | 122.1 | – | – |
| Cyanidin 3-O-(2G-glucosylrutinoside) 2 | – | 16.1 | – | – |
| Cyanidin 3-O-(2G-xylosylrutinoside)2 | – | – | 1312.0 * | – |
| Cyanidin 3-O-sambubioside 2 | ||||
| Pelargonidin 3-O-rutinoside 2 | – | – | 37.4 | – |
| Sum of contents | – | 208.6 | 2797.5 | – |
| Others—phenolic acids, flavonoids | ||||
| Gallic acid | – | – | – | 20.7 |
| Caffeic acid | – | – | – | 74.9 |
| Protocatechic acid | – | – | 15.4 | 20.6 |
| Epicatechin | 65.5 | – | – | 1538.2 |
| Quercetin 3-O-glucuronide | 15.7 | 10.1 | 74.4 | 166.9 |
| β-hemolytic Streptococcus Group A PCM465 | β-hemolytic Streptococcus Group B | Staphylococcus aureus ATCC6538 | Staphylococcus epidermidis ATCC14990 | Enterococcus hirae ATCC10541 | Enterococcus faecalis ATCC51299 | Corynebacterium dyphtheriae | Cadida albicans ATCC10248 | |
|---|---|---|---|---|---|---|---|---|
| Oxacillin | N | N | 40 ± 0.1 | 40 ± 0.2 | N | N | N | N |
| Penicillin | 58 ± 0.05 | 12 ± 0.1 | 26 ± 0.2 | 10 ± 0.2 | 6 ± 0.00 | 6 ± 0.00 | 30 ± 0.2 | N |
| Amoxicillin | 60 ± 0.05 | 28 ± 0.05 | N | N | N | N | N | N |
| Ampicillin | N | N | N | N | 24 ± 0.1 | 22 ± 0.2 | N | N |
| Cefotaxime | 60 ± 0.13 | 6 ± 0.00 | N | N | N | N | 48 ± 0.2 | N |
| Ceftriaxone | 25 ± 0.21 | 6 ± 0.00 | N | N | N | N | 48 ± 0.25 | N |
| Cefepime | 20 ± 0.11 | 6 ± 0.00 | N | N | N | N | N | N |
| Imipenem | N | N | N | N | N | N | 6 ± 0.00 | N |
| Netilmycin | N | N | 20 ± 0.2 | 24 ± 0.2 | N | N | N | N |
| Gentamicin (CN10) | N | N | 28 ± 0.25 | 35 ± 0.2 | N | N | 50 ± 0.2 | N |
| Gentamicin (CN120) | N | N | N | N | 15 ± 0.2 | 12 ± 0.2 | N | N |
| Streptomycin (S300) | N | N | N | N | 11 ± 0.1 | 10 ± 0.1 | N | N |
| Kanamycin | N | N | 23 ± 0.22 | 23 ± 0.2 | N | N | N | N |
| Amikacin | N | N | 20 ± 0.1 | 25 ± 0.52 | N | N | N | N |
| Tobramycin | N | N | 23 ± 0.21 | 25 ± 0.3 | N | N | N | N |
| Erythromycin | 20 ± 0.2 | 15 ± 0.25 | 32 ± 0.2 | 22 ± 0.1 | N | N | 66 ± 0.34 | N |
| Telithromycin | N | N | N | N | N | N | 68 ± 0.35 | N |
| Daptomycin | 38 ± 0.21 | 18 ± 0.2 | N | N | N | N | N | N |
| Clindamycin | 38 ± 0.22 | 6 ± 0.00 | 25 ± 0.2 | 40 ± 0.23 | N | N | 50 ± 0.45 | N |
| Linezolid | 42 ± 0.1 | 32 ± 0.2 | 42 ± 0.1 | 50 ± 0.2 | 30 ± 0.2 | 26 ± 0.26 | 70 ± 0.55 | N |
| Ofloxacillin | 28 ± 0.25 | 12 ± 034 | 32 ± 0.21 | 20 ± 0.25 | N | N | N | N |
| Ciprofloxacin | N | N | 40 ± 0.3 | 45 ± 0.3 | N | N | N | N |
| Levofloxacin | 28 ± 0.31 | 22 ± 0.25 | 39 ± 0.25 | 25 ± 0.25 | N | N | N | N |
| Vancomycin | N | N | 25 ± 0.2 | 26 ± 0.31 | 20 ± 0.36 | 14 ± 0.15 | 40 | N |
| Teicoplanin | 28 ± 0.1 | 16 ± 0.2 | 20 ± 0.2 | 25 ± 0.1 | 20 ± 0.2 | 15 ± 0.2 | N | N |
| Fusidic acid | N | N | 25 ± 0.2 | 40 ± 0.1 | N | N | N | N |
| Rifampicin | N | N | 40 ± 0.13 | 50 ± 0.22 | 29 ± 0.21 | 20 ± 0.26 | 50 ± 0.2 | N |
| Cotrimoxazole | N | N | 35 ± 0.2 | 30 ± 0.22 | N | N | 29 ± 0.21 | N |
| Mupirocin | N | N | 30 ± 0.35 | 35 ± 0.22 | N | N | N | N |
| Tetracycline | 35 ± 0.2 | 10 ± 0.21 | 25 ± 0.2 | 10 ± 0.11 | 25 ± 0.15 | 20 ± 0.32 | 40 ± 0.1 | N |
| Tigecycline | 32 ± 0.21 | 18 ± 0.21 | N | N | N | N | N | N |
| Chloramphenicol | N | N | 35 ± 0.1 | 19 ± 0.25 | 29 ± 0.2 | 9 ± 0.11 | N | N |
| Miconazole | N | N | N | N | N | N | N | 14 ± 0.1 |
| Caspafungin | N | N | N | N | N | N | N | 15 ± 0.1 |
| Nystatin | N | N | N | N | N | N | N | 22 ± 0.1 |
| Econazole | N | N | N | N | N | N | N | 15 ± 0.1 |
| Extract of Rubus occidentalis “Litacz” fruits | 9 ± 0.5 * | 9 ± 0.5 * | 19 ± 0.1 * | 23 ± 0.1 * | 6 ± 0.1 | 6 ± 0.1 | 20 ± 0.1 * | 6 ± 0.1 |
| Extract of Rubus idaeus “Laszka” fruits | 10 ± 0.5 * | 9 ± 0.8 * | 20 ± 0.1 * | 24 ± 0.1 * | 6 ± 0.1 | 6 ± 0.1 | 19 ± 0.1 * | 6 ± 0.1 |
| Extract of Rubus idaeus“ Poranna Rosa” fruits | 10 ± 0.5 * | 11 ± 0.3 * | 24 ± 0.1 * | 25 ± 0.1 * | 6 ± 0.1 | 6 ± 0.1 | 22 ± 0.1 * | 6 ± 0.1 |
| Extract of Rubus idaeus “Willamette” shoot | 13 ± 0.1 * | 10 ± 0.1 * | 23 ± 0.1 * | 25 ± 0.1 * | 6 ± 0.1 | 6 ± 0.1 | 25 ± 0.1 * | 6 ± 0.1 |
| Escherichia coli ATCC8739 | Klebsiella pneumoniae ATCC13883 | Proteus vulgaris ATCC13883 | Pseudomonas aeruginosa ATCC9027 | Acinetobacter baumanii 2021 | Stenotrophomonas maltophilia12755 | Helicobacter pylori ATCC10231 | |
|---|---|---|---|---|---|---|---|
| Amoxicillin | 30 ± 0.21 | 7 ± 0.1 | 25 ± 0.21 | N | N | N | 24 ± 0.2 |
| Amoxicillin/clavulanic acid | 25 ± 0.12 | 11 ± 0.2 | 24 ± 0.12 | N | N | N | N |
| Ampicillin | 20 ± 0.2 | 6 ± 0.00 | 24 | N | N | N | N |
| Ampicillin/sulbactam | N | N | N | 6 ± 0.00 | 6 ± 0.00 | N | N |
| Cefuroxime | 26 ± 0.12 | 20 ± 0.23 | 25 ± 0.23 | N | N | N | N |
| Cefotaxime | 25 ± 0.2 | 28 ± 0.22 | 25 ± 0.1 | N | N | N | N |
| Ceftriaxone | 24 ± 0.25 | 25 ± 0.21 | 26 ± 0.21 | N | N | N | N |
| Cefazolin | 30 ± 0.24 | 25 ± 0.1 | 20 ± 0.00 | N | N | N | N |
| Ceftazidime | N | N | N | 31 ± 0.23 | N | 30 ± 0.5 | N |
| Cefepime | 40 ± 0.2 | 20 ± 0.23 | 21 ± 0.2 | 20 ± 0.05 | 16 ± 0.2 | N | N |
| Ticarcillin | 25 ± 0.12 | 12 ± 0.12 | 28 ± 0.21 | 25 ± 0.1 | 16 ± 0.2 | N | N |
| Ticarcillin/clavulanic acid | 25 ± 0.2 | 24 ± 0.2 | 35 ± 0.2 | 30 ± 0.21 | N | N | N |
| Piperacillin | 35 ± 0.21 | 28 ± 0.2 | 28 ± 0.21 | N | N | N | N |
| Piperacillin/tazobactam | 32 ± 0.2 | 29 ± 0.2 | 35 ± 0.13 | 37 ± 0.2 | 30 | N | N |
| Imipenem | 25 ± 0.12 | 7 ± 0.05 | 19 ± 0.12 | 30 ± 0.2 | 6 ± 0.00 | N | N |
| Meropenem | 33 ± 0.1 | 20 ± 0.2 | 18 ± 0.13 | 30 ± 0.2 | 6 ± 0.00 | N | N |
| Ertapenem | 33 ± 0.21 | 17 ± 0.2 | 18 ± 0.21 | N | N | N | N |
| Doripenem | 31 ± 0.22 | 6 ± 0.00 | 20 ± 0.21 | N | N | N | N |
| Aztreonam | 25 ± 0.2 | 6 ± 0.00 | 24 ± 0.1 | 35 ± 0.2 | N | N | N |
| Clarithromycin | N | N | N | N | N | N | 8 ± 0.12 |
| Netilmicin | 17 ± 0.25 | N | 25 ± 0.1 | 22 ± 0.11 | 20 ± 0.1 | N | N |
| Gentamicin | 19 ± 0.2 | N | 25 ± 0.23 | 18 ± 0.12 | N | N | N |
| Amikacin | 18 ± 0.1 | 26 ± 0.2 | 26 ± 0.21 | 25 ± 0.2 | N | N | N |
| Tobramycin | 19 ± 0.1 | 10 ± 0.1 | 29 ± 0.12 | N | N | N | N |
| Ciprofloxacin | 35 ± 0.26 | N | 40 ± 0.35 | 40 ± 0.35 | N | N | N |
| Levofloxacin | N | N | N | 36 ± 0.56 | N | 35 ± 0.6 | 30 ± 0.35 |
| Tetracycline | 28 ± 0.2 | 28 ± 0.2 | 18 ± 0.34 | N | N | N | 35 ± 0.1 |
| Tigecycline | 20 ± 0.1 | N | 20 ± 0.1 | N | N | N | N |
| Chloramphenicol | 31 ± 0.2 | 30 ± 0.1 | 28 ± 0.1 | 18 ± 0.2 | 15 ± 0.2 | N | N |
| Colistin | N | N | N | 17 ± 0.1 | 14 ± 0.1 | 18 ± 0.1 | N |
| Metronidazole | N | N | N | N | N | N | 6 ± 0.00 |
| Cotrimoxazole | 20 ± 0.2 | 35 ± 0.35 | 25 ± 0.25 | N | N | 15 ± 0.25 | N |
| Extract of Rubus occidentalis “Litacz” fruits | 6 ± 0.1 | 6 ± 0.1 | 6 ± 0.1 | 6 ± 0.1 | 6 ± 0.1 | 6 ± 0.1 | 6 ± 0.1 |
| Extract of Rubus idaeus “Laszka” fruits | 6 ± 0.1 | 6 ± 0.1 | 6 ± 0.1 | 6 ± 0.1 | 6 ± 0.1 | 6 ± 0.1 | 6 ± 0.1 |
| Extract of Rubus idaeus “Poranna Rosa” fruits | 6 ± 0.1 | 6 ± 0.1 | 6 ± 0.1 | 6 ± 0.1 | 6 ± 0.1 | 6 ± 0.1 | 6 ± 0.1 |
| Extract of Rubus idaeus “Willamette” shoot | 6 ± 0.1 | 6 ± 0.1 | 6 ± 0.1 | 6 ± 0.1 | 6 ± 0.1 | 6 ± 0.1 | 6 ± 0.1 |
Disclaimer/Publisher’s Note: The statements, opinions and data contained in all publications are solely those of the individual author(s) and contributor(s) and not of MDPI and/or the editor(s). MDPI and/or the editor(s) disclaim responsibility for any injury to people or property resulting from any ideas, methods, instructions or products referred to in the content. |
© 2024 by the authors. Licensee MDPI, Basel, Switzerland. This article is an open access article distributed under the terms and conditions of the Creative Commons Attribution (CC BY) license (https://creativecommons.org/licenses/by/4.0/).
Share and Cite
Hałasa, R.; Mizerska, U.; Kula, M.; Krauze-Baranowska, M. Screening Tests for the Interaction of Rubus idaeus and Rubus occidentalis Extracts with Antibiotics against Gram-Positive and Gram-Negative Human Pathogens. Antibiotics 2024, 13, 653. https://doi.org/10.3390/antibiotics13070653
Hałasa R, Mizerska U, Kula M, Krauze-Baranowska M. Screening Tests for the Interaction of Rubus idaeus and Rubus occidentalis Extracts with Antibiotics against Gram-Positive and Gram-Negative Human Pathogens. Antibiotics. 2024; 13(7):653. https://doi.org/10.3390/antibiotics13070653
Chicago/Turabian StyleHałasa, Rafał, Urszula Mizerska, Marta Kula, and Mirosława Krauze-Baranowska. 2024. "Screening Tests for the Interaction of Rubus idaeus and Rubus occidentalis Extracts with Antibiotics against Gram-Positive and Gram-Negative Human Pathogens" Antibiotics 13, no. 7: 653. https://doi.org/10.3390/antibiotics13070653
APA StyleHałasa, R., Mizerska, U., Kula, M., & Krauze-Baranowska, M. (2024). Screening Tests for the Interaction of Rubus idaeus and Rubus occidentalis Extracts with Antibiotics against Gram-Positive and Gram-Negative Human Pathogens. Antibiotics, 13(7), 653. https://doi.org/10.3390/antibiotics13070653

